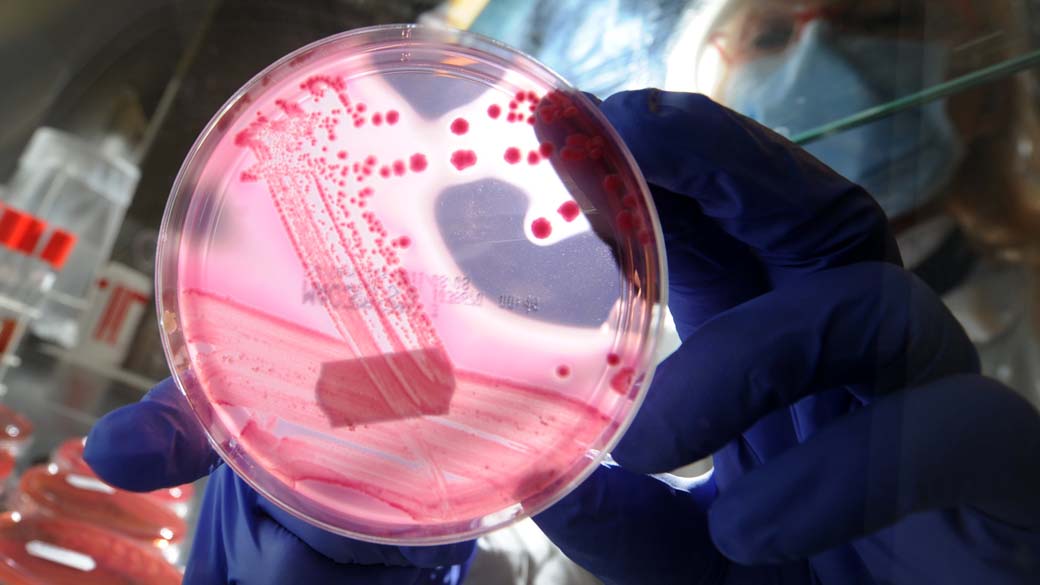

Conheça as 10 bactérias mais estudadas nos laboratórios – e as inúmeras ignoradas
Quase três quartos de todos os microrganismos conhecidos nunca foram investigados em profundidade
As bactérias estão entre os primeiros microrganismos a surgirem na Terra, há cerca de 3,5 bilhões de anos. Seu sucesso foi tamanho que, hoje, elas não somente continuam por aqui como estão por toda parte e são essenciais para a evolução do planeta e para a sobrevivência dos seres vivos. Um estudo divulgado agora, contudo, revela que, do ponto de vista científico, esse ainda é um mundo a ser explorado.
De acordo com um artigo pré-print, disponibilizado no repositório bioRxiv, enquanto dez espécies bacterianas, sozinhas, equivalem a metade de todas as publicações científicas sobre microrganismos, quase três quartos de todas as bactérias conhecidas não tem nenhum artigo a respeito delas. “Nós aprendemos muito sobre um pequeno número de espécies”, diz Paul Jensen, autor do estudo, em entrevista à Nature.
Quais são as dez bactérias mais estudadas?
De fato, apenas uma espécie, a famosa Escherichia coli, corresponde a mais de 20% de todos os artigos publicados. E há uma razão para isso. “As bactérias mais estudadas causam uma infinidade de problemas e são muito mais frequentes, talvez por isso elas chamem mais atenção”, diz Clara Bastos, pesquisadora de doutorado em biologia celular, molecular e bioagentes patogênicos da Universidade de São Paulo (USP). São elas:
- Escherichia coli – 21%
- Staphylococcus aureus – 8,8%
- Pseudomonas aeruginosa – 4,9%
- Mycobacterium tuberculosis – 3,9%
- Helicobacter pylori – 3,0%
- Bacillus subtilis – 2,4%
- Klebsiella pneumoniae – 2,0%
- Streptococcus pneumoniae – 1,9%
- Listeria monocytogenes – 1,4%
- Haemophilus influenzae – 1,2%
A maior parte dessas bactérias, como explicado, é responsável por complicações comuns e há muito conhecidas pela humanidade, como tuberculose e infecções respiratórias, intestinais ou sexualmente transmissíveis.
Isso, por si só, justifica o grande número de estudos a respeito dessas bactérias. A questão, contudo, é que das 43 mil espécies conhecidas, cerca de 74% nunca foi investigada em profundidade. “Um dos problemas disso é que muitos microrganismos patogênicos são subnotificados por não serem conhecidos ou identificados a tempo”, explica Bastos.
E isso não passa apenas pelos pesquisadores. Na ciência, de maneira geral, é preciso conseguir financiamento para conduzir pesquisas e, para isso, os cientistas são obrigados a convencer agências e empresas de que aquela investigação é relevante – algo que reforça a construção de conhecimento a respeito daquilo que já é estudado e desestimula a pesquisa científica sobre organismos ainda pouco conhecidos.
[abril-veja-tambem]W3siaWQiOjU2Nzc4MzksInRpdGxlIjoiQ2llbnRpc3RhcyBkZXNjb2JyZW0gY29tbyB1bSBmdW5nbyBkcmlibGEgbm9zc2EgaW11bmlkYWRlIHBhcmEgY2F1c2FyIGRvZW4mI3hFNzthcyJ9LHsiaWQiOjUwNTIxNzksInRpdGxlIjoiTyBxdWUgYSBxdWFsaWRhZGUgZG8gc29sbyB0ZW0gYSB2ZXIgY29tIGEgc3VhIHNhJiN4RkE7ZGUgaW50ZXN0aW5hbD8ifSx7ImlkIjo0NDAyNDc3LCJ0aXRsZSI6IkNpZW50aXN0YXMgZGVzY29icmVtIGNvbW8gbWljcm9iaW90YSBpbnRlc3RpbmFsIHByb3RlZ2UgY29ycG8gZGUgcGF0JiN4RjM7Z2Vub3MifV0=[/abril-veja-tambem]
Por que estudar bactérias pouco famosas?
O estudo realizado por Bastos é um exemplo disso. Ela investiga um microrganismo conhecido como Chromobacterium violaceum. Na plataforma Pubmed, a mesma utilizada por Jansen para fazer o levantamento, existem apenas 1215 artigos sobre essa bactéria – a critério de comparação, a Coxiella burnetti, 50ª na lista de mais estudadas, tem mais de 4 mil.
Mas por que investigar a “Chromo”, como foi apelidada pelo grupo que a pesquisadora compõe? Hoje, essa é uma infecção considerada rara em humanos, mas quando ocorre, apresenta uma alta taxa de mortalidade. “Estima-se que muitos casos não são notificados, já que é possível que a pessoa venha a óbito antes que se descubra sobre a infecção”, explica a pesquisadora.
E isso também vale para outros microrganismos. Segundo o autor, muitas das bactérias presentes no microbioma de humanos saudáveis não figuram entre os mais estudados. “Nenhum dos microrganismos dominantes da natureza está na lista”, diz Jansen. “Isso é um problema.”
Uma maior investigação sobre eles só será benéfica. Além de revelar detalhes sobre os microrganismos que fazem mal para humanos, animais e plantas, um conhecimento melhor desses seres – que, importante ressaltar, estão em todos os lugares – também pode beneficiar outros seres vivos, o equilíbrio dos microbiomas e até processos industriais.
 SEGUIR
SEGUIR
 SEGUINDO
SEGUINDO





















